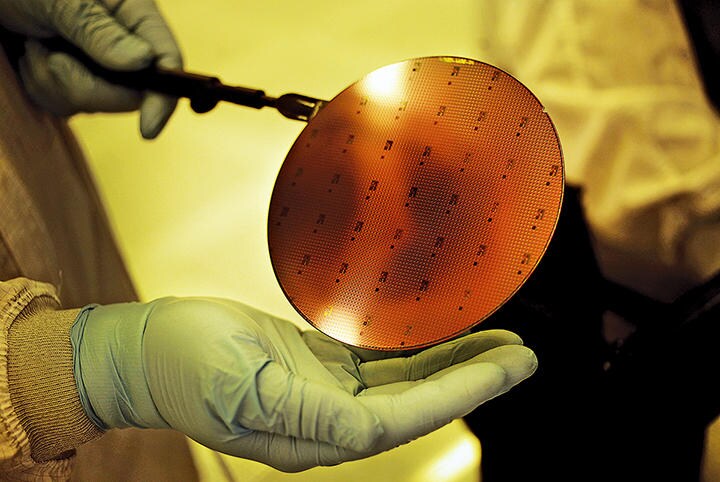
magSR200615_ColdWars4.jpg

将来、多くの産業を支配しようとする中国のあからさまな野心は、中国市場に魅せられて多額の投資を行った世界各国の多国籍企業にとっては厄介な問題だ。中国の急速な技術的進歩が今後も続くなら、アメリカなどの諸外国の多国籍企業はそのうち、中国市場から完全に追い出されてしまうだろう。
「中国製造2025とは要するに、アメリカ企業を追い払い、アメリカ企業が売っているあらゆる価値ある製品をわが物にするということだ」と、『中国、通商および権力──西側の経済的働き掛けはなぜ失敗したか』の著者であるスチュワート・パターソンは言う。
トランプが課した追加関税と中国の野心を前に、アメリカの多国籍企業やアメリカの政策立案に関わる人々はある問いを胸に抱くようになった。アメリカは経済的に中国と距離を置くべきなのではないか?
そこに新型コロナウイルスの感染拡大と中国の対応が追い打ちをかけた。トランプの貿易戦争は経済的「デカップリング(切り離し)」へのゆっくりとした動きのきっかけをつくった。つまりそれほど高度な技術を必要としない利幅の小さい製品を扱う産業では、高関税を嫌って生産拠点を中国から移す動きが出ているのだ。繊維製品や靴、家具などを製造する企業においては中国離れの動きが特に目立つ。
パンデミック前とは大違いだ。在中国・米国商工会議所が中国で事業を行うアメリカ企業を対象に昨年10月に行った調査では、66%がデカップリングは不可能だと答えていた。ところが最近の調査では、デカップリングは不可能だと答えた企業の割合は44%に下落している。
トランプの顧問らによれば、再選されたあかつきにトランプは医薬品や医療機器以外の業界にも生産をアメリカに戻せと、何らかの形で圧力をかける可能性が高いという。実際にどんな形を取るかはまだ分からないが、側近たちは日本の例が参考になると考えている。日本政府は先頃、サプライチェーンの国内回帰を支援するため、総額2200億円の補助金を補正予算に組み込んだ。
アメリカ国内で中国に対する否定的な見方が強まるなか、企業経営者たちは厳しい選択を迫られている。パターソンの言葉を借りれば「敵と商売をしているとみられたいか否か」ということだ。
答えはさほど簡単ではない。多くの米企業は中国との付き合いを減らしたくないと考えている。何年もかけ、多額の投資をして築いたサプライチェーンを失いたくないのだ。
例えば、アメリカが今も中国に技術的な優位を保つ半導体産業。中国市場を手放せば、米半導体メーカーは世界のシェアを約18%失い、合計で売り上げが推定37%減ることになる。売り上げが減れば、研究開発にしわ寄せがいく。米企業は過去10年間に外国勢の2倍を上回る3120億ドルを研究開発に投じ、それにより先端技術で世界をリードしてきた。